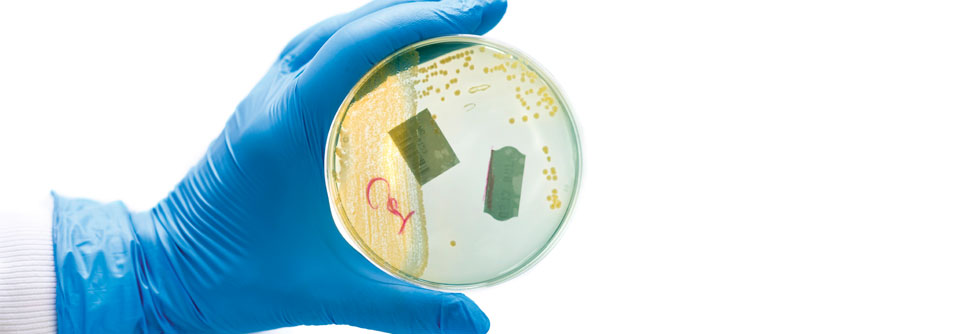

Harnwegsinfektion: Prophylaxe aus dem Wasserhahn
 Ein großer Wasserdurchlauf verringert offenbar die Bakterienbelastung.
© Pixabay
Ein großer Wasserdurchlauf verringert offenbar die Bakterienbelastung.
© Pixabay
Wer eine Blasenentzündung hat oder erst gar keine bekommen möchte, sollte viel trinken, lautet ein wohlbekannter Rat. Aber ist da überhaupt was dran? An wissenschaftlichen Belegen für die Volksweisheit mangelte es bisher jedenfalls. Nun hat sich ein Forscherteam um Dr. Thomas M. Hooton von der University of Miami in einer randomisierten klinischen Studie mit dem Thema beschäftigt.
Dazu untersuchten die Wissenschaftler 140 prämenopausale Frauen, die mit weniger als 1,5 Litern pro Tag eher wenig tranken. Alle Probandinnen hatten im Vorjahr an mindestens drei Blasenentzündungen gelitten. Über einen Zeitraum von zwölf Monaten nahmen die 70 Frauen der Interventionsgruppe täglich 1,5 Liter Wasser zusätzlich zu ihrer gewohnten Trinkmenge zu sich. Die Kontrollgruppe hingegen blieb weiterhin bei ihrer gewohnten Ration.
Tatsächlich sank in der Gruppe der Wassertrinkerinnen die Zahl der Harnwegsinfektionen um etwa 50 %. Während es bei diesen Frauen zu insgesamt 111 Blasenentzündungen kam, lag die Zahl der Zystitiden in der Kontrollgruppe bei 216. Auch der Bedarf an Antibiotika ging spürbar zurück (1,9 versus 3,6 Verordnungen). Zudem waren die Zeitabstände zwischen den Zystitisepisoden in der Interventionsgruppe deutlich größer als bei den Kontrollpersonen (142,8 versus 84,4 Tage).
Vermutlich führen das gesteigerte Urinvolumen mit den häufigeren Toilettengängen sowie die geringere Osmolarität des Harns zu den positiven Effekten, schreiben die Autoren. Durch die erhöhte Flüssigkeitszufuhr werde die Blase besser gespült und die Bakterienbelastung verringert.
Quelle: Hooton T et al. JAMA Intern Med 2018; online first